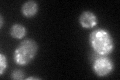
YDR264C
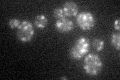
YDR264C

View description
Palmitoyl transferase involved in protein palmitoylation; acts as a negative regulator of pheromone response pathway; required for endocytosis of pheromone receptors; involved in cell shape control; contains ankyrin repeats
Localization:
Intensity:
Fold change:
Significance:
-
C’ GFP library in SD

punctate44.12 -
N' NOP1pr-GFP in SD

N/A0 -
N' TEF2pr-mCherry in SD

N/A0 -
N' NATIVEpr-GFP in SD

N/A0 -
N' TEF2pr-VC and Cyto-VN in SD

N/A0 -
C’ GFP library in SD+DTT
punctate39.710.9No -
C’ GFP library in SD+H2O2

punctate46.761.05No -
C’ GFP library in Starvation Media
punctate43.080.97No -
C’ GFP library on the background of Pup2-DaMP

punctate -
C’ GFP library on the background of CCT mutant

punctate40.61760.920433No
